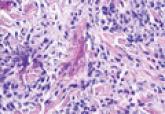

Article

Enlarging Pigmented Lesion on the Thigh
- Author:
- Thomas Helm, MD
Publish date: August 7, 2023
Quiz

Rapidly Enlarging Noduloulcerative Lesions
- Author:
- Thomas Helm, MD
Publish date: September 22, 2014
Article
Wells Syndrome
- Author:
- Thomas Helm, MD
Publish date: January 2, 2014